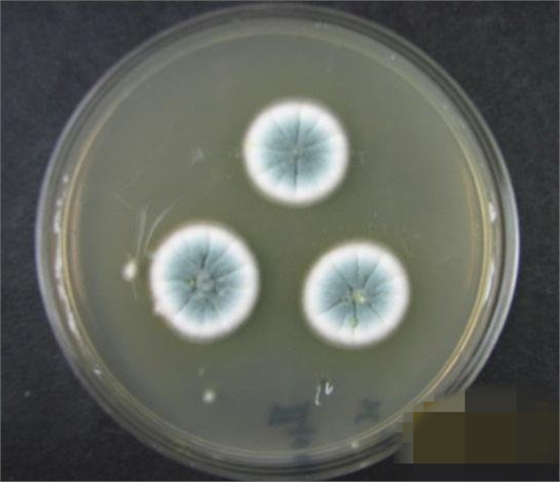
4.jpg

億昌菌業(yè)食用菌病蟲害防治課堂開課了
一、為什么食用菌會發(fā)生病蟲害?
因?yàn)槭秤镁L發(fā)育的環(huán)境條件與病蟲害的孽生繁殖條件大體一致;再加上栽培基質(zhì)、菌絲體及子實(shí)體的氣味和栽培場的光源對飛蟲具有吸引性,所以,食用菌栽培和病蟲害的發(fā)生具有—定的必然性和相關(guān)性。
二、食用菌病害的主要種類有哪些?
食用菌病害分侵染性病害和非侵染性病害(生理性病害)兩類。
(1)侵染性病害也稱傳染性病害,主要包括競爭性雜菌、真菌
性病害、細(xì)菌性病害和病毒性病害等。其中危害最多的是競爭性雜菌,簡稱雜菌,常見有木霉、鏈孢霉、青霉、曲霉、毛霉、根霉、酵母菌、細(xì)菌、放線菌等。其特點(diǎn)是污染培養(yǎng)基質(zhì),在基質(zhì)上與食用菌菌絲競爭生長,爭奪養(yǎng)分和生存空間,并抑制食用菌菌絲生長,導(dǎo)致菌種制作失敗或栽培減產(chǎn),甚至絕收。用高效綠霉凈殺滅,效果極好


鏈孢霉 綠霉

毛霉菌 根霉
(2)生理性病害主要是指由于生長環(huán)境不合適如通風(fēng)差、濕度大等,造成的菌絲體或子實(shí)體生長出現(xiàn)的異常現(xiàn)象。
三、食用菌蟲害的主要種類有哪些?
在食用菌生產(chǎn)過程中以及食用菌干品儲藏期間都會發(fā)生蟲害,嚴(yán)重影響產(chǎn)量和子實(shí)體品質(zhì),有效防治各種害蟲是保證食用菌栽培高產(chǎn)、優(yōu)質(zhì)的重要環(huán)節(jié)。
危害食用菌的害蟲主要有昆蟲、線蟲、螨類及軟體動物等。


吃菌絲的昆蟲平菇螨蟲類


平菇眼菌蚊線蟲
四、食用菌病蟲害的防治原則是什么?
食用菌屬于綠色、健康保健食品,它的獨(dú)特生產(chǎn)方式和子實(shí)體較短的生長周期,要求生產(chǎn)者不能在子實(shí)體生長階段噴灑任何化學(xué)藥劑,必須把“防”放在第一位。采取“預(yù)防為主,防重于治,綜合防治”的方針,減少化學(xué)藥劑的使用,以確保食用菌生產(chǎn)的高產(chǎn)、優(yōu)質(zhì)和高效,創(chuàng)造真正的綠色產(chǎn)品和無公害品牌。
五、如何做到食用菌病蟲害的綜合防治呢?
綜防措施有四個層面意思:一是切斷病蟲害傳播途徑;二是農(nóng)藝防治措施;三是化學(xué)防治措施;四是環(huán)境控制措施。
六、如何做才能切斷病蟲害傳播途徑?
食用菌栽培中病蟲害的來源途徑有三條:菌種帶蟲、帶病原、培養(yǎng)料或覆土帶蟲卵、帶病原;菇房(棚)內(nèi)外自然傳播。切斷這三
條傳播渠道是綜防措施的重中之重。
菌諾寶利E+
菌諾寶利 U+〔注水型〕
菌諾寶利C+〔注水型〕
菌諾寶利C+(拌料型)